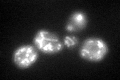
YPL183W-A

View description
Homolog of the prokaryotic ribosomal protein L36, likely to be a mitochondrial ribosomal protein coded in the nuclear genome; null mutation suppresses cdc13-1 temperature sensitivity
Localization:
Intensity:
Fold change:
Significance:
-
C’ GFP library in SD

mitochondria60.59 -
N' NOP1pr-GFP in SD

N/A0 -
N' TEF2pr-mCherry in SD

N/A0 -
N' NATIVEpr-GFP in SD

N/A0 -
N' TEF2pr-VC and Cyto-VN in SD

N/A0 -
C’ GFP library in SD+DTT
mitochondria55.910.92No -
C’ GFP library in SD+H2O2

mitochondriaN/AN/ANo -
C’ GFP library in Starvation Media

mitochondria56.60.93No -
C’ GFP library on the background of Pup2-DaMP

mitochondria -
C’ GFP library on the background of CCT mutant

mitochondria37.10750.612359Yes
